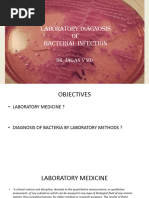

0% found this document useful (0 votes)
7 views5 pagesPost-Lab Con
The document outlines the preparation and classification of various culture media used in microbiology, including nutrient agar, broth, and specialized media for isolating specific bacteria. It details inoculation techniques, aseptic methods, and the effects of UV light on microbial growth, emphasizing the importance of maintaining sterility and accurate media preparation for effective diagnosis and treatment of infections. Additionally, it discusses the impact of pH on bacterial growth and the significance of different staining methods for identifying microorganisms.
Uploaded by
Mark MatsumotoCopyright
© © All Rights Reserved
We take content rights seriously. If you suspect this is your content, claim it here.
Available Formats
Download as PDF, TXT or read online on Scribd
0% found this document useful (0 votes)
7 views5 pagesPost-Lab Con
The document outlines the preparation and classification of various culture media used in microbiology, including nutrient agar, broth, and specialized media for isolating specific bacteria. It details inoculation techniques, aseptic methods, and the effects of UV light on microbial growth, emphasizing the importance of maintaining sterility and accurate media preparation for effective diagnosis and treatment of infections. Additionally, it discusses the impact of pH on bacterial growth and the significance of different staining methods for identifying microorganisms.
Uploaded by
Mark MatsumotoCopyright
© © All Rights Reserved
We take content rights seriously. If you suspect this is your content, claim it here.
Available Formats
Download as PDF, TXT or read online on Scribd
/ 5